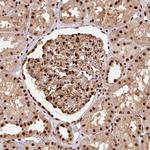
EVI1 Antibody in Immunohistochemistry (Paraffin) (IHC (P))
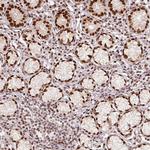
EVI1 Antibody in Immunohistochemistry (Paraffin) (IHC (P))

Search
Invitrogen
EVI1 Polyclonal Antibody
{{$productOrderCtrl.translations['antibody.pdp.commerceCard.promotion.promotions']}}
{{$productOrderCtrl.translations['antibody.pdp.commerceCard.promotion.viewpromo']}}
{{$productOrderCtrl.translations['antibody.pdp.commerceCard.promotion.promocode']}}: {{promo.promoCode}} {{promo.promoTitle}} {{promo.promoDescription}}. {{$productOrderCtrl.translations['antibody.pdp.commerceCard.promotion.learnmore']}}
产品信息
PA5-83826
种属反应
宿主/亚型
分类
类型
抗原
偶联物
形式
浓度
规格
纯化类型
保存液
内含物
保存条件
运输条件
RRID
产品详细信息
Immunogen sequence: ATSSPHSELE STGAILDDKE DAYFTEIRNF IGNSNHGSQS PRNVEERMNG SHFKDEKALV TSQNSDLLDD EEVEDEVLLD EEDEDNDITG KTGKEPVTSN LHEGNPEDDY EETSALEMSC KTSPVRYKEE EY
Highest antigen sequence indentity to the following orthologs: Mouse - 86%, Rat - 87%.
靶标信息
EVI1 (MECOM) is a transcriptional regulator and oncoprotein that may be involved in hematopoiesis, apoptosis, development, cell differentiation, and proliferation. It can interact with CTBP1, SMAD3, CREBBP, KAT2B, MAPK8, and MAPK9. The EVI1 gene can undergo translocation with the AML1 gene, resulting in overexpression of the EVI1 gene and the onset of leukemia. Several transcript variants encoding a few different isoforms have been found for this gene.
仅用于科研。不用于诊断过程。未经明确授权不得转售。
篇参考文献 (0)
生物信息学
蛋白别名: AML1-EVI-1 fusion protein; Ecotropic virus integration site 1 protein homolog; EVI-1; Histone-lysine N-methyltransferase MECOM; MDS1; MDS1 and EVI1 complex locus protein; MDS1 and EVI1 complex locus protein EVI1; MDS1 and EVI1 complex locus protein MDS1; MGC163392; MGC97004; Myelodysplasia syndrome 1 protein; Myelodysplasia syndrome-associated protein 1; oncogene EVI1; OTTHUMP00000213163; OTTHUMP00000213164; OTTHUMP00000213165; OTTHUMP00000213187; OTTHUMP00000213192; PR domain 3; unnamed protein product; zinc finger protein Evi1
基因别名: AML1-EVI-1; EVI1; KMT8E; MDS1; MDS1-EVI1; MECOM; PRDM3; RUSAT2
UniProt ID: (Human) Q03112
Entrez Gene ID: (Human) 2122